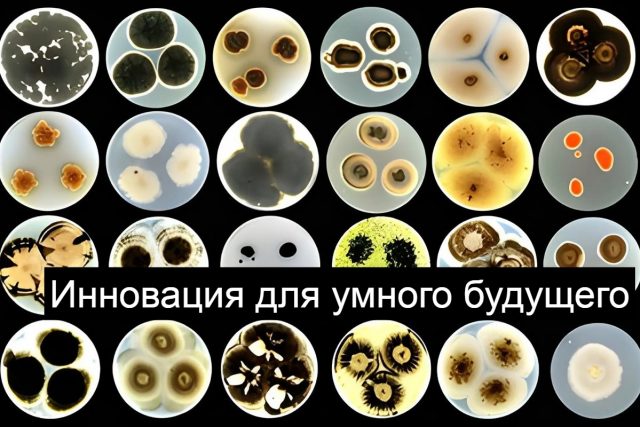
zhivaya-tatuirovka-axcE (1)

Учёные из Южной Кореи разработали искусственный синапс, используя природные материалы. Устройство, имитирующее работу мозга, потребляет рекордно мало энергии и полностью разлагается в почве после использования. Разработка может стать основой для экологически чистых нейроморфных чипов и ИИ-устройств нового поколения.
Современные электронные компоненты, включая искусственные синапсы для систем ИИ, требуют значительных объёмов энергии и вносят вклад в проблему электронных отходов. Большинство таких устройств изготавливаются из трудно перерабатываемых материалов.
Команда Ульсанского национального института науки и технологий создала полностью биоразлагаемый искусственный синапс. Он способен воспроизводить механизмы обучения и памяти, характерные для человеческого мозга.
Чип представляет собой микроскопическую многослойную структуру, собранную исключительно из природных материалов. В ней используются ионно-активные слои, полученные из бобов и панцирей ракообразных, а центральное ионосвязывающее ядро изготовлено из ацетата целлюлозы на основе растительных волокон. Дополнительные элементы включают хитин и другие натуральные полимеры.
При подаче электрического импульса устройство высвобождает ионы натрия, которые имитируют действие нейромедиаторов в биологическом мозге. Эти ионы закрепляются внутри структуры за счёт ионно-дипольных взаимодействий, позволяя синапсу сохранять информацию даже без питания и формировать как кратковременную, так и долговременную память.
Эксперименты показали, что искусственный синапс способен удерживать информацию до 6000 секунд, или около 100 минут, — рекорд среди биоразлагаемых аналогов. При этом энергопотребление устройства составляет всего 0,85 фемтоджоуля на сигнал, что ниже показателей человеческого мозга, который обычно потребляет 2,4-24 фемтоджоуля на одно событие.
Чтобы показать практический потенциал технологии, исследователи интегрировали синапс в простую роботизированную систему. При обнаружении тепла движение ионов внутри устройства усиливало сигнал, заставляя роботизированную руку мгновенно отдёргиваться — аналог базового человеческого рефлекса.
После завершения работы все слои чипа полностью разлагаются в почве всего за 16 дней, не оставляя токсичных следов. Такая технология открывает путь к созданию обучаемых и адаптивных ИИ-устройств, которые смогут безопасно взаимодействовать с окружающей средой и исчезать после выполнения своей задачи.